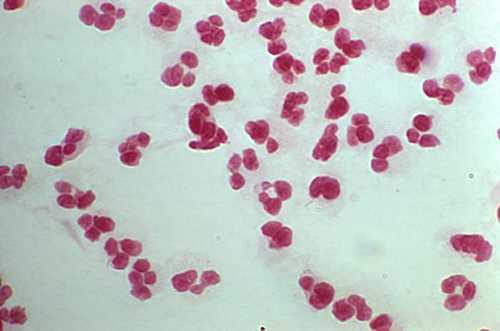
Neisseria gonorrhoeae

Культуральные свойства гонореи. Культуры гонококков. Свойства гонококков. Биохимические свойства гонококков.
Добавил пользователь Morpheus Обновлено: 11.12.2025
Медицинская микробиология:
Антигены и генетика гонококка (N. gonorrhoeae)
а) Антигены гонококка. Антигенные свойства гонококка определяются белками его клеточной стенки и входящими в ее состав ЛОС. Поверхностные белки гонококка многочисленны и весьма изменчивы. Среди них вычленяют белки, общие для двух видов патогенных нейссерий (белок NspA и белок Rmp). Остальные белки являются типоспецифическими и штаммоспецифическими.
К их числу относятся порины (Por-белки или Р1). Имеются две генетические разновидности Por-белка: Р1.А и Р1.В. Внутри каждой выявлены антигенные разновидности, обозначаемые арабскими цифрами: 1,2,3 и т.д. На основании Рог-белков гонококки разделяют на серотипы, число которых постоянно увеличивается. Типовую специфичность штамма гонококка обозначают двумя символами, например, Р1.А-6 или Р1.В-1. Серотип удается выявить только при помощи моноклональных антител или генетическими методами. Крайне изменчивыми антигенами являются белки пилей.
Во-первых, они не всегда имеются; во-вторых, имеющиеся пили постоянно изменяют свою структуру и, следовательно, антигенную специфичность. Эта изменчивость проявляется и в организме больного, и при пересевах в искусственных условиях.
Такими же непостоянными являются Ора-белки. Описано до 10 вариантов Ора-белков (А, В, С, D и т.д.). При этом они или переходят один в другой (например, из Ора А в Ора В), или один штамм имеет одновременно несколько Ора-белков, или они вообще отсутствуют. Антигенными свойствами обладают также железосвязывающие белки.
Специфическим антигеном является и ЛОС, однако его антигенная активность невелика по причине сходства с гликосфинголипидами эритроцитов человека. Иммунная система «не узнает» этот антиген и не отвечает на него выработкой антител. При этом ЛОС также непостоянны, изменяя количество входящих в них сахаров.
Изменчивость антигенов гонококка позволяет ему «ускользать» от выработанных иммунной системой антител. Антигенный состав гонококка регулируется его генетическим аппаратом, получающим сигналы из окружающей среды (тканей и жидкостей человека) при ее изменениях.

б) Генетика гонококка. Геном гонококка расшифрован, что позволило объяснить природу изменчивости его антигенов. Она связана с высокой частотой мутаций (10 3 в среднем на одну генерацию), а также с рекомбинациями — обменом между отдельными особями генетическим материалом, высвобождающимся при аутолизе клеток. Не исключаются рекомбинации и с соседствующими бактериальными клетками — представителями рода нейссерий. В процессе генетической трансформации участвуют пили, передающие экзогенную ДНК в клетку.
Возникшие новые генетические клоны, содержащие незнакомые организму больного (и контактирующих с ним лиц) антигены, получают преимущество при циркуляции среди населения и какое-то время беспрепятственно распространяются. К тому времени, когда к ним выработаются антитела, появляются новые генетические антигенные разновидности, в отношении которых эти антитела уже бесполезны.
У гонококков найдена конъюгативная плазмида размером 36 kb, а также плазмида резистентности к пенициллину (бета-лактамазная), транспозон устойчивости к тетрациклину и криптическая плазмида 4,2 kb.
в) Внутривидовое разнообразие. Изменчивость антигенов гонококка приводит к гетерогенности вида, причем его разновидности непостоянны — клоны быстро рассыпаются и дают начало новым, таким же разнообразным. Как уже указывалось, исследователям удалось все-таки выявить серотипы по пориновым антигенам, а также ауксотипы — по потребностям в ряде соединений. На основе сочетаний этих двух признаков была создана смешанная классификация вида по сероауксотипам. Их насчитывают более 70. Однако типирование гонококка на практике технически затруднительно (требует моноклональных антител и питательных сред строго определенного состава).
Культуральные свойства гонореи. Культуры гонококков. Свойства гонококков. Биохимические свойства гонококков.
Гонорея. Возбудитель гонореи. Гонококк. Эпидемиология гонореи. Источник гонореи. Морфология гонококков. Тинкториальные свойства гонококков.
Гонорея — инфекционное венерическое заболевание, проявляющееся воспалением слизистых оболочек преимущественно мочеполовых путей. Гонококк — возбудитель гонореи, инфекционного венерического заболевания, проявляющегося воспалением слизистых преимущественно мочеполовых путей. Термин «гонорея» [от греч. gone, семя, + (-rirhoia, истечение] ввёл Клавдий Галён во II веке н.э., хотя заболевание было известно ещё раньше — в вавилонских, ассирийских и греческих мифах упоминается болезнь, представляющая, судя по клинической картине, гонорею. В настоящее время гонорея — одно из наиболее распространённых инфекционных заболеваний. Возбудитель гонореи — Neisseria gonorrhoeae (гонококк) — впервые обнаружен Найссером в 1879 г.
Гонококк. Эпидемиология гонореи. Источник гонореи.
Источник гонореи — больной человек. Основной путь заражения гонореей — половой, возможно инфицирование плода при прохождении через родовые пути матери. Врождённая невосприимчивость отсутствует. После перенесённого заболевания невосприимчивость к вторичным заражениям не вырабатывается; возможны супер- и ре инфекции.
Животные резистентны к гонококкам, лишь внутрибрюшинное введение микробов вызывает гибель мелких лабораторных животных.

Морфология и тинкториальные свойства гонореи
В свежих культурах гонококки представляют неподвижные диплококки размером 1,25-1,0x0,7-0,8 мкм, образующие капсулу .
Характерен полиморфизм гонококков — в мазках встречают относительно мелкие или крупные клетки, а также палочковидные формы. Хорошо окрашиваются анилиновыми красителями (метиленовым синим, бриллиантовым зелёным и др.). Образуют L-формы, в том числе под действием пенициллина. Под влиянием химиопрепаратов быстро меняют свойства и образуют грамположительные формы. Гонококки имеют сложно организованную клеточную стенку; наличие тех или иных её компонентов обусловливает их внутривидовую дифференцировку. По наличию пилей гонококки разделяются на пять типов (Т1-Т5).
Гонококки типов Т1 и Т2 снабжены пилями (Р+ и Р++), окружены капсулой и вирулентны, бактерии прочих типов авирулентны. Белок 1 составляет до 60% вещества клеточной мембраны и его идентификация составляет основу серотипирова-ния гонококков и распознавания бактерий методом ИФА. Белок II определяет специфические клинические проявления заболевания. Бактерии содержащие белки 1 и II обычно выделяют при поражениях мочевыводящих путей, а штаммы, содержащие белок I, но лишённые белка И — при диссеминированных поражениях.
Информация на сайте подлежит консультации лечащим врачом и не заменяет очной консультации с ним.
См. подробнее в пользовательском соглашении.
Гонококк1
Возбудителя гонореи – инфекционного венерического заболевания с воспалительными проявлениями в мочеполовых путях открыл Альберт Нейссер в 1879 г. Первые культуры получили Лейстков и Леффлер (1882 г.), этиологическую роль доказал Бумм (1885).
Таксономия.
Семейство – Neisseriaceae Род – Neisseria Вид – N. gonorrhoeae
Морфология.
В свежих культурах гонококки представляют собой диплококки бобовидной формы, размером 1,25-1,0 х 0,7-0,8 мкм., образующие микрокапсулу. Жгутиков не имеют, спор не образуют. Хорошо окрашиваются анилиновыми красителями (метиленовым синим, бриллиантовым зеленым и др.). По Граму окрашиваются отрицательно. Образуют L- формы, в том числе и под действием пенициллина. Под влиянием химиопрепаратов могут быстро менять свойства и образовывать грамположительные формы. По наличию пилей гонококки разделяются на 5 типов. Ранее их обозначали Т1-Т5, сейчас Р + ,Р ++ , Р +++ … Бактерии типов Р + ,Р ++ снабжены нитями, имеют капсулу и вирулентны, бактерии прочих типов авирулентны.
В составе клеточной мембраны (стенки) содержится до 60 % белка I, на его основе осуществляется серотипирование гонококком методом ИФА. Кроме белка I, имеется белок II, который определяет специфичность клинических проявлений заболевания.
Культуральные свойства.
По типу дыхания - аэробы. Хемоорганотрофы. Требовательны к питательным средам. Растут на свежеприготовленных, влажных питательных средах с добавлением нативного белка (кровь, сыворотка, асцитическая жидкость). Оптимум рН 7,2-7,4; температуры - 37 0 С. Большинство свежевыделенныхштаммов для роста нуждаются в присутствии в атмосфере 4-10% СО2. При дальнейшем культивировании эти свойства утрачиваются.
На плотных питательных средах через 24 часа инкубирования гонококки, содержащие в клеточной стенке белок II, образуют прозрачные колонии в виде капелек росы (диаметром 1-3 мм) с ровным краем.
На жидких питательных средах растут диффузно и образуют поверхностную пленку, через несколько дней оседающую на дно.
Биохимическая активность.
Гонококки разлагают только глюкозу с образованием кислоты, образуют каталазу и цитохромоксидазу – типичные для нейссерий ферменты. Протеолитических свойств не имеют (аммиак, сероводород, индол не образуют), не вызывают гемолиза на кровяном агаре, на средах с добавлением молока, желатина и картофеля не растут.
Антигенная структура.
а) капсульные антигены;
в) белки клеточной оболочки – на их основании выделяют 16 антигенных серотипов;
Факторы патогенности.
Токсины. Гонококки не продуцируют экзотоксинов. Клеточная стенка содержит липополисахарид – эндотоксин, который оказывает токсическое воздействие.
- Структурные и химические компоненты:
а) капсула – обладает антифагоцитарным свойством, препятствует прямому контакту бактерицидных веществ с клеточной стенкой, маскирует ее антигенные детерминанты;
б) пили – обеспечивают адгезию гонококков к клеткам эпителия, что имеет решающее значение в развитии инфекции;
в) Ig А1 – протеаза. Гонококки синтезируют Ig А1 – протеазу, действующую внеклеточно и разрушающую пропин-треониновые связи в тяжелых цепях Ig, а также расщепляющую молекулу Ig в шарпирной части. Эти эффекты инактивируют антитела, препятствующие адгезии, что облегчает приклепление гонококков к рецепторам эпителиальных клеток, а также защищает их от фагоцитоза, опосредованного антителами;
г) способность к синтезу β – лактамаз.
Резистентность.
Гонококки неустойчивы во внешней среде, вне организма человека быстро погибают. При нагревании до 56 0 С гибнут за 5 мин., низкие концентрации перманганата калия (1:50) и нитрата серебра (1:10000), сулемы, карболовой кислоты губительно влияют на гонококков. Последние плохо переносят высушивание, УФЛ. Они чувствительны к антибиотикам (β – лактамные, аминогликозиды). Однако повышение заболеваемости гонореей связывают и с появлением пенициллинорезистентных штаммов гонококков.
Эпидемиология.
Источник инфекции – больной человек. Основной путь заражения – контактный половой, возможно инфицирование плода при прохождении через инфицированные родовые пути матери. Отмечены редкие случаи заражения при несоблюдении элементарных правил личной гигиены. Врожденная невосприимчивость отсутствует.
Роль в патологии
Гонококки вызывают гонореюу мужчин и женщин и являются возбудителями бленнореи новорожденных.
Патогенез
Гонорея – инфекционное венерическое заболевание, проявляющееся воспалением слизистых оболочек преимущественно половых путей. Термин гонорея (от греч. gone – семя, +rhoia – истечение) ввел К. Гален во II в. н.э. В настоящее время гонорея – одно из наиболее распространенных инфекционных заболеваний. Гонококки поражают, в основном, клетки цилиндрического эпителия. У новорожденных могут вызывать бленнорею (конъюктивит). При экстрагенитальной локализации могут поражать прямую кишку и миндалины.Они
прикрепляются к цилиндрическому эпителию уретры, влагалищной части шейки матки, прямой кишки, конъюктивы глаза, а также к сперматозоидам и простейшим (трихомонады, амебы). Адгезия происходит за счет пилей и белков наружной мембраны клеточной стенки. Характерной особенностью гонококков является их способность проникать в лейкоциты и размножаться в них. Липополисахаридная часть клеточной стенки бактерий оказывает токсическое действие на организм человека. Капсулярные полисахариды подавляют фагоцитоз. Соединяясь с ворсинками цилиндрического эпителия слизистой уретры, а у женщин - и эндоцервикального канала, гонококки проникают внутрь клетки при участии белков наружной мембраны клеточной стенки. Это приводит к развитию острого уретрита, цервицита и поражению у женщин шейки матки, воспалению придатков (трубы, яичники), у мужчин происходит воспаление семенных семенных пузырьков, предстательной железы.
Иммунитет.
После перенесенного заболевания иммунитет не вырабатывается. Врожденная невосприимчивость к гонорее отсутствует, возможны супер- и реинфекции. Единственный чувствительный организм – человек. До сих пор остается неясным вопрос, почему антитела, определяемые в сыворотке больного (агглютинины, преципитины, опсонины), не обеспечивают защиту от повторного заражения.
Профилактика. Средства специфической иммунопрофилактики отсутствуют, что обусловлено высокой антигенной изменчивостью гонококков. Гоновакцина, на которую возлагалось много надежд, оказалась неэффективной. Общая профилактика основана на мерах предупреждения венерических заболеваний. Для предупреждения гонобленореи новорожденным сразу после рождения закапывают в конъюктивальный мешок (девочкам также в половую щель) 1-2 капли раствора сульфацила натрия или антибиотика (пенициллины, цефалоспарины)
Лечение.
Основу терапии составляет антимикробная терапия. Препараты выбора – сульфаниламиды и антибиотики, подавляющие жизнедеятельность гонококков (β – лактальные антибиотики, аминогликозиды). Для лечения хронических или осложненных форм гонореи используют гоновакцину.
Микробиологическая диагностика.
Наиболее распространенным методом является бактериоскопическое исследование. Выделение чистой культуры проводится сравнительно редко, главным образом, при хронической гонорее, когда бактериоскопия дает отрицательный результат. Кроме того, в настоящее время используют РИФ и ПЦР. Серодиагностика при хронической гонорее (РСК) проводится редко
Лекция № 10. Стрептококки. Гонококки, менингококки
В семейство Streptococcaceae входит семь родов, из которых для человека наибольшее значение имеют стрептококки (род Streptococcus) и энтерококки (род Enterococcus). Наиболее значимые виды - S.pyogenes (стрептококки группы А), S.agalactiae (стрептококки группы В), S.pneumoniae (пневмококк), S.viridans (зеленящие стрептококки, биогруппа mutans), Enterococcus faecalis.
Морфология. Стрептококки (от греч. streptos - цепочка и coccus - зерно) - грамположительные цитохромнегативные бактерии шаровидной или овоидной формы, растущие чаще в виде цепочек, преимущественно неподвижные, не имеют спор. Патогенные виды образуют капсулу (у пневмококка имеет диагностическое значение). Факультативные (большинство) или строгие анаэробы.
Культуральные свойства. Стрептококки плохо растут на простых питательных средах. Обычно используют среды с кровью или сывороткой крови. Чаще применяют сахарный бульон и кровяной агар, содержащий 5% дефибринированной крови. На бульоне рост придонно - пристеночный в виде крошковатого осадка, бульон чаще прозрачен. На плотных средах чаще образуют очень мелкие колонии. Оптимум температуры +37 о С, рН - 7,2-7,6. На плотных средах стрептококки группы А образуют колонии трех типов:
- мукоидные (напоминают капельку воды) - характерны для вирулентных штаммов, имеющих капсулу;
- шероховатые - плоские, с неровной поверхностью и фестончатыми краями - характерны для вирулентных штаммов, имеющих М- антигены;
- гладкие - характерны для маловирулентных штаммов.
Предпочитают газовую смесь с 5% СО2. Способны образовывать L- формы.
Для дифференциации стрептококков используют различные признаки: рост при +10 о и 45 о С, рост на среде с 6,5% NaCl, рост на среде с рН 9,6, рост на среде с 40% желчи, рост в молоке с 0,1% метиленовым синим, рост после прогревания в течение 30 мин. при 60 о С. Наиболее распространенный S.pyogenes относится к 1 группе (все признаки отрицательны), энтерококки (3 группа) - все признаки положительны.
Существует ряд классификаций стрептококков. Наиболее проста классификация, основанная на особенностях роста этих микроорганизмов на агаре с кровью барана (по отношению к эритроцитам).
Бета - гемолитические стрептококки при росте на кровяном агаре образуют вокруг колонии четкую зону гемолиза, альфа - гемолитические - частичный гемолиз и позеленение среды (превращение окси- в метгемоглобин), гамма- гемолитические - на кровяном агаре гемолиза незаметно. Альфа - гемолитические стрептококки за зеленый цвет среды называют S.viridans (зеленящими).
Антигенная структура. Серологическая классификация имеет практическое значение для дифференциации имеющих сложное антигенное строение стрептококков. В основе классификации - группоспецифические полисахаридные антигены клеточной стенки. Выделяют 20 серогрупп, обозначенных заглавными латинскими буквами. Наибольшее значение имеют стрептококки серогрупп А,В и D.
У стрептококков серогруппы А имеются типоспецифические антигены - белки М, Т и R. По М- антигену гемолитические стрептококки серогруппы А подразделены на серовары (около 100).
Стрептококки имеют перекрестно - реагирующие антигены с антигенами клеток базального слоя эпителия кожи, эпителиальных клеток корковой и медуллярной зон тимуса. В клеточной стенке стрептококков обнаружен также антиген (рецептор II), способный взаимодействовать с Fс- фрагментом IgG.
Факторы патогенности стрептококков.
1. Белок М- главный фактор. Определяет адгезивные свойства, угнетает фагоцитоз, определяет типоспецифичность, обладает свойствами суперантигена. Антитела к М- белку обладают протективными свойствами.
2. Капсула - маскирует стрептококки за счет гиалуроновой кислоты, аналогичной гиалуроновой кислоте в тканях хозяина.
3. С5а - пептидаза - расщепляет С5а - компонент комплемента, чем снижает хемоатрактивную активность фагоцитов.
4. Стрептококки вызывают выраженную воспалительную реакцию, в значительной степени обусловленную секрецией более 20 растворимых факторов - ферментов (стрептолизины S и О, гиалуронидаза, ДНК- азы, стрептокиназа, протеазы) и эритрогенных токсинов.
Эритрогенин - скарлатинозный токсин, обусловливающий за счет иммунных механизмов образование ярко красной скарлатинозной сыпи. Выделяют три серологических типа этого токсина (А,В и С). Токсин обладает пирогенным, аллергенным, иммуносупрессивным и митогенным действием.
Генетика. Мутации и рекомбинации менее выражены, чем у стафилококков. Способны синтезировать бактериоцины. Фаги для дифференциации не применяют.
Эпидемиологические особенности. Основными источниками являются больные острыми стрептококковыми инфекциями (ангина, пневмония, скарлатина), а также реконвалесценты. Механизм заражения - воздушно - капельный, реже - контактный, очень редко - алиментарный.
Клинико - патогенетические особенности. Стрептококки - обитатели слизистых верхних дыхательных путей, пищеварительного и моче - полового трактов, вызывают различные заболевания эндо- и экзогенного характера. Выделяют локальные (тонзиллит, кариес, ангины, отиты и др.) и генерализованные инфекции (ревматизм, рожистое воспаление, скарлатина, сепсис, пневмония, стрептодермии и др.). Развитие тех или иных форм зависит от ряда условий, в т.ч. от входных ворот, различных факторов патогенности, состояния иммунной системы (особую роль играют антитоксины и типоспецифические М- антитела).
Особое положение в роде Streptococcus занимает вид S.pneumoniae (пневмококк) - этиологический агент крупозной пневмонии, острых и хронических воспалительных заболеваний легких. От остальных стрептококков отличается морфологией (чаще диплококки в форме пламени свечи, плоскими концами друг к другу, обладают выраженной капсулой), антигенной специфичностью (имеют 83 серовара по капсульному полисахаридному антигену), высокой чувствительностью к желчи и оптохину, вызывают альфа - гемолиз. Главный фактор патогенности - полисахаридная капсула.
Скарлатину вызывают различные серотипы бета - гемолитических стрептококков, обладающих М- антигеном и продуцирующих эритрогенин (токсигенные стрептококки серогруппы А). При отсутствии антитоксического иммунитета возникает скарлатина, при наличии - ангина.
Лабораторная диагностика. Основной метод диагностики - бактериологический. Материал для исследования - кровь, гной, слизь из зева, налет с миндалин, отделяемое ран. Решающим при исследовании выделенных культур является определение серогруппы (вида). Группоспецифические антигены определяют в реакции преципитации, латекс - агглютинации, коагглютинации, ИФА и в МФА с моноклональными антителами (МКА). Серологические методы чаще используют для диагностики ревматизма и гломерулонефрита стрептококковой этиологии - определяют антитела к стрептолизину О и стрептодорназе.
Грамотрицательные аэробные и факультативно - анаэробные кокки.
Наибольшее значение имеет род Neisseria, из видов - N.gonorrhoeae - гонококк и N.meningitidis - менингококк, остальные виды нейссерий - комменсалы.
Морфология. Нейссерии - диплококки, напоминающие кофейные зерна или бобы, прилегающие друг к другу уплощенными сторонами. Для них характерно наличие капсулы, а также пилей и ворсинок, облегчающих адгезию патогенных нейссерий к эпителию.
Культуральные особенности. Для культивирования патогенные нейссерии требуют среды с кровью, сывороткой крови или асцитической жидкостью человека. Каждый вид избирательно ферментирует углеводы. Оптимальная температура +37 о С, рН- 7,2-7,4. Для культивирования пригодны кровяной и шоколадный агар с добавлением крахмала, нужна повышенная концентрация CO2, селективные компоненты, подавляющие рост сопутствующей микрофлоры.
Гонококк - возбудитель гонореи - венерического заболевания с воспалительными проявлениями в моче- половых путях. Субстрат для колонизации - эпителий уретры, прямой кишки, конъюнктивы глаза, глотки, шейки матки, маточных труб и яичника.
Диплококки, хорошо окрашиваемые метиленовым синим и другими анилиновыми красителями, плеоморфные (полиморфизм). Очень прихотливы к условиям культивирования и питательным средам. Из углеводов ферментируют только глюкозу.
Антигенная структура очень изменчива - характерны фазовые вариации (исчезновение антигенных детерминант) и антигенные вариации (изменение антигенных детерминант). Основную антигенную нагрузку несут детерминанты пилей и поверхностных белков. С высокой антигенной изменчивостью связано отсутствие иммунной защиты против повторного заражения. Наибольшее антигенное родство - с менингококками.
Факторы патогенности. Основными факторами являются пили, с помощью которых гонококки осуществляют адгезию и колонизацию эпителиальных клеток слизистой оболочки моче- половых путей, и липополисахарид (эндотоксин, освобождающийся при разрушении гонококков). Гонококки синтезируют IgAI- протеазу, расщепляющую IgA.
Генетика. Характерна генетическая изменчивость, даже на протяжении жизни одной микробной популяции. Передача информации осуществляется преимущественно конъюгацией. Выявлены F- и R- плазмиды, в т.ч. плазмиды, несущие ген бета - лактамазы.
Лабораторная диагностика. Бактериоскопическая диагностика включает окраску по Граму и метиленовым синим. Типичные признаки гонококка - грамотрицательная окраска, бобовидные диплококки, внутриклеточная локализация. При антибиотикотерапии, хронической гонорее и некоторых других случаях как морфологические признаки, так и отношение к окраске по Граму может изменяться. Более достоверна люминесцентная диагностика с использованием прямого и непрямого иммунофлюоресцентного анализа.
Посев производят на специальные среды (КДС- МПА из мяса кролика или бычьего сердца с сывороткой, асцит- агар, кровяной агар). Характерные признаки гонококка при бактериологической диагностике - грамотрицательные диплококки, колонии которых на плотных средах обладают оксидазной активностью. Ферментируют глюкозу, но не мальтозу или сахарозу.
Менингококк - возбудитель менингококковой инфекции - строгого антропоноза с воздушно - капельной передачей возбудителя. Основной источник - носители. Природный резервуар - носоглотка человека. Морфологические, культуральные и биохимические свойства аналогичны гонококку. Отличия - ферментируют не только глюкозу, но и мальтозу, продуцируют гемолизин. Обладают капсулой, имеющей большие размеры и другое строение, чем у гонококка.
Антигенный состав. Имеют четыре основные антигенные системы.
1. Капсульные группоспецифические полисахаридные антигены. Штаммы серогруппы А наиболее часто вызывают эпидемические вспышки.
2. Белковые антигены наружной мембраны. По этим антигенам менингококки серогрупп В и С подразделены на классы и серотипы.
3. Родо- и видоспецифические антигены.
4. Липополисахаридные антигены (8 типов). Имеют высокую токсичность, вызывают пирогенное действие.
Факторы патогенности. Факторы адгезии и колонизация - пили и белки наружной мембраны. Факторы инвазивности - гиалуронидаза и другие продуцируемые ферменты (нейраминидаза, протеазы, фибринолизин). Большое значение имеют капсульные полисахаридные антигены, защищающие микроорганизмы от фагоцитоза.
Иммунитет стойкий, антимикробный.
Лабораторная диагностика основана на бактериоскопии, выделении культуры и ее биохимической идентификации, серологических методах диагностики. Посев материала производят на твердые и полужидкие питательные среды, содержащие кровь, асцитическую жидкость, сыворотку крови.
Оксидаза- позитивные культуры рассматривают как принадлежащие к роду Neisseria. Для менингококка характерна ферментация глюкозы и мальтозы. Принадлежность к серогруппе определяют в реакции агглютинации (РА). Для обнаружения антигенов может также применяться реакция коагглютинации, латекс- агглютинации, ИФА, для серодиагностики - РНГА с группоспецифическими полисахаридными антигенами
Neisseria gonorrhoeae (гонококк)
Гонококк (Neisseria gonorrhoeae) — вид аэробных, грамотрицательных, не образующих спор бактерий. Клетки неподвижны и имеют вид кофейных зёрен, размером 0,7-0,8 на 1,0-1,25 мкм. Оптимальная температура среды для культивирования гонококков — 37°С, кислотность — 7,2-7,4 рН. Чаще всего располагаются попарно. Возбудитель гонореи.
Гонорея
В большинстве случаев Neisseria gonorrhoeae вызывает воспаление, ограничивающееся мочеполовыми органами, сопровождающееся выделениями и субъективными расстройствами. Встречается гонорея прямой кишки (ректальная гонорея, гонококковый проктит), изредка гонорея глаз, глотки, миндалин, очень редко — генерализация инфекции.
Передача происходит чаще всего при вагинальном, оральном или анальном половом акте. Новорожденные инфицируются при прохождении плода через родовые пути матери, больной гонореей. Бытовым путём практически не передаётся.
В зависимости от течения заболевания, Neisseria gonorrhoeae могут претерпевать значительные изменения. При остром процессе обе половинки диплококка имеют одинаковую величину и расположены внутриклеточно, а при хроническом — разную и расположены внеклеточно. При неблагоприятных условиях гонококки могут переходить в L-формы, изменяя форму и размер — крупные шаровидные или мелкие пылевые частицы. При ассимиляции с уреаплазмами Neisseria gonorrhoeae переходит в малоактивную фазу и становятся защищенными от действия антибиотиков и от фагоцитоза. При трихомонадной инфекции в сочетании с гонореей Neisseria gonorrhoeae малоактивны и персистируют внутри трихомонад.
Всемирная организация здравоохранения в своём релизе от 07.7.2017 года отмечает: «По оценкам каждый год гонореей заражается 78 миллионов человек. Гонорея поражает слизистую половых органов, прямой кишки и горла. От осложнений гонореи в диспропорционально большой степени страдают женщины. К таким осложнениям относятся воспаление органов таза, внематочная беременность и бесплодие, а также более высокий риск заражения ВИЧ.
Всё более распространенным явлением является устойчивость к старым и менее дорогостоящим антибиотикам. В некоторых странах – особенно, странах с высоким уровнем доходов, где эпидемиологический надзор наиболее эффективен, – были отмечены случаи инфекции, не поддающиеся лечению ни одним из известных сегодня антибиотиков».
Лечение гонореи
- цефтриаксон — 250 мг внутримышечно однократно
- азитромицин — 1 г внутрь однократно — 400 мг внутрь однократно
- ципрофлоксацин — 500 мг внутрь однократно
- спектиномицин — 4 г внутримышечно однократно
- цефуроксим — 1,5 г внутримышечно однократно
- цефуроксим аксетил — 1 г внутрь однократно
- пефлоксацин — 600 мг внутрь однократно
- ломефлоксацин — 600 мг внутрь однократно — 800 мг внутрь однократно
- цефтриаксон — 1 г внутримышечно или внутривенно каждые 24 часа
- цефотаксим — 1 г внутривенно каждые 8 часов
- канамицин — 1 млн ЕД внутримышечно каждые 12 часов
- ципрофлоксацин — 500 мг внутривенно каждые 12 часов
- ципрофлоксацин — 500 мг внутрь через каждые 12 часов
- пефлоксацин — 400 мг внутрь через каждые 12 часов
- офлоксацин — 400 мг внутрь через каждые 12 часов
- ломефлоксацин — 400 мг внутрь через каждые 12 часов
- доксициклин — 0,1 г внутрь каждые 12 часов
- метациклин — 0,3 г внутрь каждые 6 часов
Neisseria gonorrhoeae устойчива к клиндамицину.
Гонорея в США
В США каждый год регистрируется примерно 820 000 новых случаев гонореи. Развившаяся устойчивость гонококков ко многим антибактериальным средствам уменьшает шансы на излечение и увеличивает риск развития осложнений. Neisseria gonorrhoeae в настоящее время устойчива к пенициллинам, тетрациклинам и сульфаниламидам. С 2007 г. из-за распространения и роста резистентности Neisseria gonorrhoeae к фторхинолонам последние более не рекомендуются для применения при гонорее. Единственным оставшимся классом антибиотиков с высоким уровнем активности против Neisseria gonorrhoeae остаются цефалоспорины.
- при неосложнённой гонореи шейки матки, уретры и прямой кишки, одновременно, первый, предпочтительный, вариант:
- цефтриаксон — 250 мг однократно внутримышечно
- азитромицин — 1 г однократно внутрь
Источник: Committee Opinion No. 645 Summary: Dual Therapy for Gonococcal Infections. Obstet Gynecol. 2015 Nov;126(5):1126. doi: 10.1097/AOG.0000000000001144.
Гонококковый фарингит
![Резистентные к антибиотикам Neisseria gonorrhoeae]()
Гонококковый фарингит (gonococcal infections of the pharynx) вызывается Neisseria gonorrhoeae, в том числе пенициллин-резистентным, и гигантскими L-формами. Инкубационный период — менее недели. Субъективная симптоматика при гонококковом фарингите зачастую отсутствует, то есть заболевание часто протекает, с точки зрения ощущений больного, практически бессимптомно. В острую стадию возможны боль в глотке при глотании, ощущения сухости, першения, наличия инородного тела в глотке, гипертермия, недомогание, утомляемость. При фарингоскопии определяются гиперемия и отечность слизистой оболочки ротоглотки, увеличенные лимфоидные фолликулы на задней стенке глотки, налеты желтоватого или сероватого оттенков. Характерен регионарный лимфаденит. Сочетанное течение гонококкового фарингита и гингивита помимо перечисленных симптомов проявляется также кровоточивостью десен и неприятным запахом изо рта. При хроническом течении гонорейного фарингита больного беспокоят упорный кашель, дисфагия. Окончательный диагноз устанавливается по результатам бактериологического исследования ротоглоточного секрета и урогенитального отделяемого. При гонорее не формируется иммунитет, возможны повторные заражения (Морозова С.В.).
Для лечения гонококковых фарингита и тонзиллита рекомендуется цефтриаксон внутримышечно 0,5-1 г однократно + азитромицин внутрь однократно. В связи с высоким риском сопутствующей хламидийной инфекции у пациентов с гонореей рекомендуется дополнительно назначать азитромицин или доксициклин.
Neisseria gonorrhoeae в систематике бактерий
Neisseria gonorrhoeae относится к роду нейссерий (лат. Neisseria), который входит в семейство Neisseriaceae, порядок Neisseriales, класс Betaproteobacteria, тип протеобактерии (Proteobacteria), царство Бактерии.
В составе вида Neisseria gonorrhoeae выделен подвид Neisseria kochii.
Читайте также:
- Сорбционные методы детоксикации по крови и плазме. Гемодиафильтрация
- Межличностная психотерапия - методы, цели
- Консервативное лечение сердечной недостаточности. Тактика при сердечной недостаточности.
- Рак фатерова сосочка. Анатомия и физиология поджелудочной железы
- Признаки сочетания грибка ногтей и псориаза

